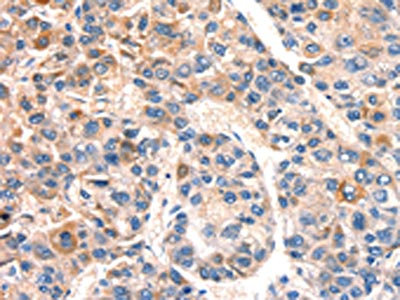

BCL3 Antibody
-
中文名稱(chēng):BCL3兔多克隆抗體
-
貨號(hào):CSB-PA971984
-
規(guī)格:¥1100
-
圖片:
-
The image on the left is immunohistochemistry of paraffin-embedded Human gastic cancer tissue using CSB-PA971984(BCL3 Antibody) at dilution 1/15, on the right is treated with synthetic peptide. (Original magnification: ×200)
-
The image on the left is immunohistochemistry of paraffin-embedded Human liver cancer tissue using CSB-PA971984(BCL3 Antibody) at dilution 1/15, on the right is treated with synthetic peptide. (Original magnification: ×200)
-
Gel: 8%SDS-PAGE, Lysate: 40 μg, Lane 1-2: A549 cells, hela cells, Primary antibody: CSB-PA971984(BCL3 Antibody) at dilution 1/333, Secondary antibody: Goat anti rabbit IgG at 1/8000 dilution, Exposure time: 10 minutes
-
-
其他:
產(chǎn)品詳情
-
Uniprot No.:
-
基因名:
-
別名:B cell CLL/lymphoma 3 antibody; B cell leukemia/lymphoma 3 antibody; B cell lymphoma 3 encoded protein antibody; B-cell lymphoma 3 protein antibody; Bcl 3 antibody; BCL 4 antibody; BCL-3 antibody; Bcl3 antibody; BCL3_HUMAN antibody; BCL4 antibody; Chronic lymphatic leukemia protein antibody; D19S37 antibody; Protein Bcl 3 antibody; Proto-oncogene BCL3 antibody
-
宿主:Rabbit
-
反應(yīng)種屬:Human,Mouse
-
免疫原:Synthetic peptide of Human BCL3
-
免疫原種屬:Homo sapiens (Human)
-
標(biāo)記方式:Non-conjugated
-
抗體亞型:IgG
-
純化方式:Antigen affinity purification
-
濃度:It differs from different batches. Please contact us to confirm it.
-
保存緩沖液:-20°C, pH7.4 PBS, 0.05% NaN3, 40% Glycerol
-
產(chǎn)品提供形式:Liquid
-
應(yīng)用范圍:ELISA,WB,IHC
-
推薦稀釋比:
Application Recommended Dilution ELISA 1:1000-1:2000 WB 1:200-1:1000 IHC 1:25-1:100 -
Protocols:
-
儲(chǔ)存條件:Upon receipt, store at -20°C or -80°C. Avoid repeated freeze.
-
貨期:Basically, we can dispatch the products out in 1-3 working days after receiving your orders. Delivery time maybe differs from different purchasing way or location, please kindly consult your local distributors for specific delivery time.
-
用途:For Research Use Only. Not for use in diagnostic or therapeutic procedures.
相關(guān)產(chǎn)品
靶點(diǎn)詳情
-
功能:Contributes to the regulation of transcriptional activation of NF-kappa-B target genes. In the cytoplasm, inhibits the nuclear translocation of the NF-kappa-B p50 subunit. In the nucleus, acts as transcriptional activator that promotes transcription of NF-kappa-B target genes. Contributes to the regulation of cell proliferation.
-
基因功能參考文獻(xiàn):
- Bcl3 overexpression could be a surrogate biomarker for NF-kappaB activation in Barrett's epithelial cells leading to deregulation of NF-kappaB-inducible gene expression, inferring resistance to apoptosis through the activation of anti-apoptotic genes such as Survivin. PMID: 29473241
- Data show that B-cell CLL-lymphoma 3 (Bcl-3) expression levels in colonic T cells correlate with disease manifestation in patients with inflammatory bowel disease. PMID: 28452361
- Bcl-3 participates in the IL-22-induced expression of STAT3-dependent late-response genes, and the combination of IL-22 and IL-17-induced psoriasis-related gene expression. PMID: 28901004
- B-cell leukemia protein 3 (Bcl3) expressed in response to cytokine TWEAK stimulation (experimental kidney injury) decreases TWEAK-induced inflammatory and lethal responses. PMID: 28684863
- Four gene signature (PTEN, PIK3C2A, ITPA and BCL3) is an independent prognostic factors of both overall survival and disease-free survival in clear-cell renal-cell carcinoma. PMID: 27779101
- Akt2, Erk2, and IKK1/2 phosphorylate Bcl3, converting Bcl3 into a transcriptional coregulator by facilitating its recruitment to DNA. PMID: 28689659
- Bcl-3 knockdown enhanced the degradation of Smad3 but not Smad2 following TGFbeta treatment. PMID: 27906182
- We have shown for the first time that BCL-3 promotes the growth of colorectal cancer cells through activation of the AKT pathway, increasing tumour cell yield both in vitro and in vivo. PMID: 26033966
- BCL3 serves as an oncogene in glioma by modulating proliferation, cell cycle progression and apoptosis, and its oncogenic effects are mediated by the STAT3 signaling pathway. PMID: 27748795
- miR-19b silencing promoted cell proliferation and cell cycle progression in gastric cancer cells and BCL3 was identified as a direct target of miR-19b PMID: 27572553
- Study confirmed that BCL-3 is overexpressed in hepatocellular carcinoma (HCC) tissues and correlated with adverse clinicopathological features and poorer prognosis. BCL-3 can promote the growth of HCC cells by promoting cell viability, proliferation and cell cycle progression through regulation of CCND1 expression. PMID: 26882953
- Bcl3 reduces the inflammatory response in pancreas/biliary tissue by blocking ubiquitination and proteasome-mediated degradation of nuclear factor-kappaB p50 homodimers. PMID: 26526716
- Variant of BCL3 gene is strongly associated with five-year survival of non-small-cell lung cancer patients PMID: 26122346
- Subcellular localization of Bcl-3 could be a potential-early diagnostic marker in colon cancer. PMID: 25929479
- Bcl-3 is involved in the development of Tfh cells and the pathogenesis of RA, presumably by inducing IL-21 production. PMID: 26138292
- Suggest the involvement of BCL3 in cardiovascular disease, which could be partly mediated through the influence on metabolic phenotypes. PMID: 25374339
- These findings suggest that the two LMP1 signaling domains modulate their combined activity and that the bcl3 transcription factor is likely responsible for some of the unique effects of CTAR1 domain on cellular expression. PMID: 25873381
- DC-SIGN directs adaptive T helper cell type-2immunity to fucose-expressing pathogens via an IKKepsilon-CYLD-dependent signalling pathway leading to Bcl3 activation. PMID: 24867235
- data show that BCL-3 makes extensive contacts with p50 homodimers and in particular with ankyrin repeats (ANK) 1, 6, and 7, and the N-terminal region of Bcl-3. PMID: 25922067
- a delayed (incoherent) feed-forward loop together with differential rates of TNFA (fast) and BCL3 (slow) mRNA turnover provide robust, pulsatile expression of TNFalpha PMID: 24130828
- Bcl-3 plays a critical role in stabilizing c-Myc protein via ERK activation. PMID: 23794716
- It protects cells from apoptosis by regulationg apoptotic pathways. PMID: 23494744
- Bcl-3 may contribute to the adult T cell leukemia development through the positive regulation of cell growth, DNA stabilization and NF-kappaB activation. PMID: 23534762
- elevated expression in patients with Crohn's disease and ulcerative colitis PMID: 23607276
- RHBDD1 could inhibit cell apoptosis by activating and upregulating c-Jun and its downstream target, Bcl-3 PMID: 23669365
- using Bcl-3 knockdown in prostate cancer cells, identified the inhibitor of DNA-binding (Id) family of helix-loop-helix proteins as potential Bcl-3-regulated genes PMID: 22580608
- Carriers of BCL3 allele rs7257231T had longer posterior cranial bases than noncarriers, and in the familial-based association test showed the statistically strongest relationship to phenotype. PMID: 23115114
- These results indicate for the first time a cell-autonomous disease-modifying role for Bcl3 in vivo, affecting metastatic disease progression rather than primary tumor growth. PMID: 23149915
- acute alcohol treatment induces molecular signatures of TLR4/LPS tolerance through the induction of Bcl-3 PMID: 22782967
- a novel mechanism for regulatory control of CTCF in UV stress-induced human corneal epithelial cells, which requires activation and formation of Bcl-3/p50 complex through a noncanonical NF-kappaB pathway PMID: 21912613
- inhibitory effect on OC cell growth was mediated by miR-125b inhibition of the translation of an mRNA encoding a proto-oncogene, BCL3 PMID: 20658525
- We validated STAT3 as a bona fide target of BCL3 in a cervical cancer cell line by additional interference RNA and in silico analyses of previously reported lymphoma patients. PMID: 20974051
- found that depleting Bcl-3 protein using shRNAs induce a decrease of proliferation and clonogenic survival associated with the induction of multinucleation and increased ploidy PMID: 20731879
- Genetic variations of UBE2L3 and BCL3 are potential new risk genes for Crohn's disease. PMID: 20601676
- this study reveals a novel combinatorial role for Bcl3 and CtBP1, providing an explanation for the acquisition of resistance to apoptosis in cancer cells, which is a major requirement for cancer development. PMID: 20800578
- Data defined a unique motif of BCL-3 that is needed for its recruitment to the proteasome and identified PSMB1 as a key protein required for the proteasome-mediated degradation of a nuclear and oncogenic IkappaB protein. PMID: 20558726
- Biochemical purification of interacting partners of BCL-3 led to the identification of CtBP as a molecule required for the ability of BCL-3 to repress gene transcription. PMID: 20547759
- NF-kB and Bcl-3 activation are prognostic in metastatic colorectal cancer PMID: 20414006
- Human T cell leukemia virus type 1 (HTLV-1) oncoprotein Tax increases Bcl3 expression, which is associated with enhanced growth of HTLV-1-infected T cells. PMID: 20471052
- Bcl-3 interacts with the pleckstrin homology domain and the phosphotyrosine binding domain of IRS-3, and that IRS-3 interacts with the ankyrin repeat domain of Bcl-3. PMID: 20226764
- JNK2 suppression of a novel JNK1/c-Jun/Bcl-3 apoptotic network hasa role in basal cancer cell survival PMID: 19806201
- High-level expression of BCL3 differentiates t(2;5)(p23;q35)-positive anaplastic large cell lymphoma from Hodgkin disease. PMID: 12456498
- BCL3 is downregulated by p53 to repress cyclin D1 and has a role in regulation of cell cycle progression PMID: 12808109
- The relatively high frequency of BCL-3 expression in some non-Hodgkin and Hodgkin lymphoma types raises the possibility that BCL-3 is involved in the pathogenesis of these tumors, and may be a target of new therapies. PMID: 15105810
- Supported by IL-12 signals, Bcl-3 enhances survival and clonal expansion of transgenic OT-1 CD8 T cells. PMID: 15634875
- Bcl-3 might participate in oncogenic pathways involving Lck PMID: 16099425
- (p52)2/Bcl-3P ternary complex, which is specifically induced in CD30-stimulated anaplasstic larage cell lymphoma, can modulate expression of apoptosis-related genes regulated by NF-kappaB. PMID: 16108830
- elevated Bcl-3 expression has an important function in classical Hodgkin lymphoma and peripheral T-cell non-Hodgkin lymphoma, in particular anaplastic large-cell lymphomas PMID: 16123212
- overexpression of BCL3 increases apoptosis, whereas BCL3-specific siRNA does not affect the viability of INA-6 cells suggesting that BCL3 is not essential for the survival of these cells PMID: 16732314
- study indicates that BCL3 translocations are not restricted to B-cell chronic lymphocytic leukemia but present in a heterogeneous group of B-cell malignancies PMID: 17495977
顯示更多
收起更多
-
相關(guān)疾病:A chromosomal aberration involving BCL3 may be a cause of B-cell chronic lymphocytic leukemia (B-CLL). Translocation t(14;19)(q32;q13.1) with immunoglobulin gene regions.
-
亞細(xì)胞定位:Nucleus. Cytoplasm. Cytoplasm, perinuclear region.
-
數(shù)據(jù)庫(kù)鏈接:
Most popular with customers
-
-
YWHAB Recombinant Monoclonal Antibody
Applications: ELISA, WB, IHC, IF, FC
Species Reactivity: Human, Mouse, Rat
-
Phospho-YAP1 (S127) Recombinant Monoclonal Antibody
Applications: ELISA, WB, IHC
Species Reactivity: Human
-
-
-
-
-